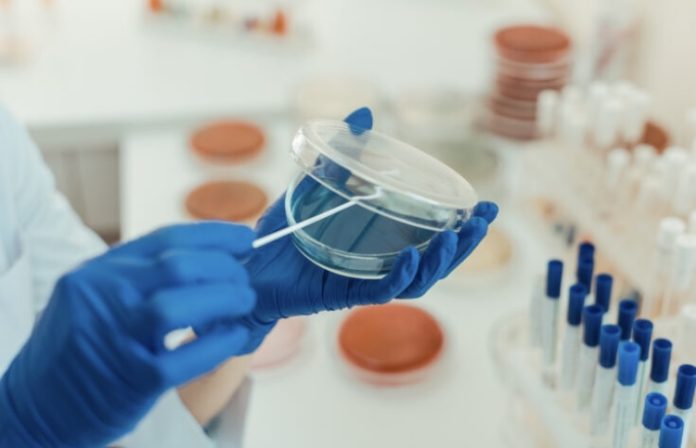

VLADIVOSTOK: Peruntukan dana sebanyak 387 juta rubel bersamaan AS$ 4.8 juta telah disediakan oleh Kerajaan Russia bagi menghasilkan MIR-19 iaitu ubat anti-COVID 19 yang telah berjaya dibangunkan oleh saintis Russia.
Dana itu secara rasminya diperuntukan untuk penghasilan MIR-19 setelah ditandatangani oleh Perdana Menteri Russia, Mikhail Mishustin.
Peruntukan dana itu seterusnya disalurkan kepada Institut Imunologi Agensi Perubatan dan Biologi Persekutuan yang bertujuan untuk menaik taraf sistem perubatan sekaligus membeli setiap peralatan yang diperlukan.
MIR-19 telah didaftarkan Kementerian Kesihatan Russia pada 22 Disember 2021 sebagai ubat yang mencegah dan merawat jangkitan COVID-19 melalui pengambilan secara pulmonari atau menerusi hidung.
MIR-19 dilihat berfungsi untuk menghalang keupayaan virus untuk terus merebak dan dapat mengelak virus terus mengembang pada peringkat awal jangkitan.